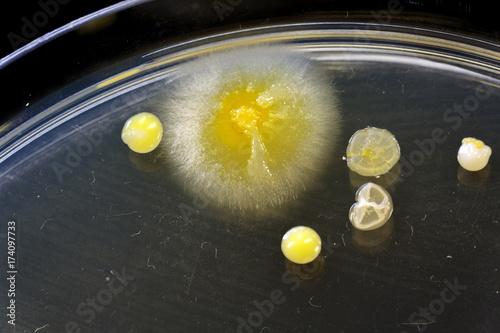
Different shaped colonies of bacteria, yeast and mold growing on agar

If you are looking for Set of basic shapes and arrangements of bacteria. Morphology you've came to the right page. We have 9 Images about Set of basic shapes and arrangements of bacteria. Morphology like Microbiology PowerPoint Template - SlideModel, Microbiology Presentation Template | Free PowerPoint Template and also Microorganisms | BioEd Online. Here you go:
Set Of Basic Shapes And Arrangements Of Bacteria. Morphology
 stock.adobe.com
stock.adobe.com bacteria morphology microbiology basic
Introduction To Medical Microbiology |authorSTREAM
microbiology medical introduction presentation authorstream dr slideshare
Different Shaped Colonies Of Bacteria, Yeast And Mold Growing On Agar
stock.adobe.com
stock.adobe.com agar colonies plates
Gram Negative Identification Flow Chart | They Are All Gram Negative
 www.pinterest.com
www.pinterest.com gram negative chart flow rods identification charts unknown
Free Biology PPT Template
 ppttemplate.net
ppttemplate.net ppt template biology
Microbiology Presentation Template | Free PowerPoint Template
 24slides.com
24slides.com microbiology template presentation templates powerpoint research
Microorganisms | BioEd Online
aspergillus microorganisms microbiology aspergillosis infection invasive microscopic fumigatus voriconazole mortality resistant associated higher disease mould close bioed bioedonline lessons
Microbiology PowerPoint Template - SlideModel
 slidemodel.com
slidemodel.com microbiology slidemodel
PPT - Propionic Acid Bacteria Enrichment PowerPoint Presentation, Free
 www.slideserve.com
www.slideserve.com propionic bacteria acid enrichment presentation ppt slideserve slide1
Microbiology presentation template. Gram negative chart flow rods identification charts unknown. Agar colonies plates